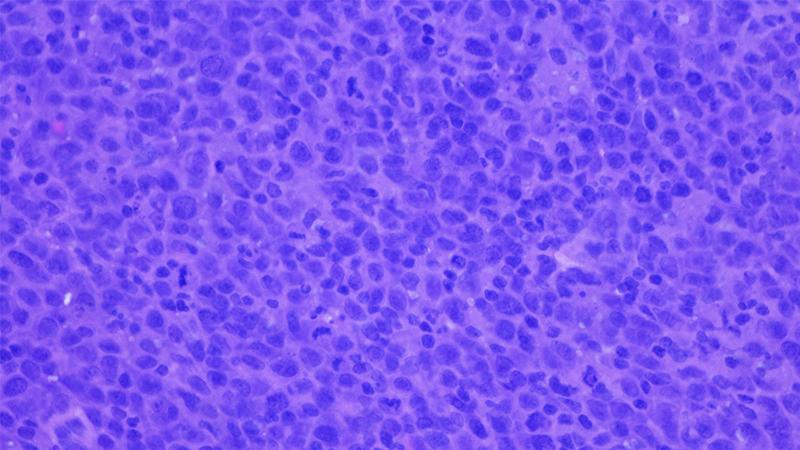
Breakthroughs in B-Cell Cancers

The 2021 Innovations in Review of clinical and scientific advances in oncology highlights NewYork-Presbyterian Hospital’s pioneering strategies for early detection and for accelerating the development of novel therapeutics to achieve the best possible outcomes for cancer patients. Clinician-scientists at Columbia's NCI-designated Herbert Irving Comprehensive Cancer Center and the Weill Cornell Medicine Meyer Cancer Center are pursuing breakthroughs that are helping to transform care in blood and solid tumor malignancies, including the most challenging cancers such as lung cancer, glioblastoma, and esophageal cancer.
Contemporary Data Analysis Promotes Personalized Cancer Therapy
Promising Treatment Emerges for Recurrent Glioblastoma
Optimizing Therapeutic Options for Patients with Lung Cancer

Contemporary Data Analysis Promotes Personalized Cancer Therapy
Scientists at Columbia and Weill Cornell Medicine are applying contemporary methods of data analysis to generate algorithms that narrow the number of genetic drivers involved in cancer development.
Using advanced mathematics and physics-based methodologies, the Columbia team analyzed data from thousands of tumor samples from all types of cancer. They found that tumors could be stratified in only 112 distinct subtypes, with tumors in each subtype controlled by the same set of master regulator proteins. Their findings confirm that master regulators provide the molecular logic that integrates the effect of many different and patient-specific mutations to implement the transcriptional state of a specific tumor subtype.
Weill Cornell Medicine researchers have developed a new algorithm, MethSig, which improves the identification of cancer-driving DNA methylation events. MethSig provides a novel statistical framework for the analysis of DNA methylation changes in cancer to specifically identify candidate DNA methylation driver genes of progression and relapse and facilitate the discovery of epigenetic mechanisms that enhance cancer cell fitness.
New methods of data analysis are generating algorithms that narrow the number of genetic drivers involved in cancer development.

Promising Treatment Emerges for Recurrent Glioblastoma
Columbia researchers led a clinical trial of selinexor, the first of a new class of anti-cancer drugs, which was able to shrink tumors in almost a third of patients with recurrent glioblastoma. The results of the international phase 2 trial were published in the January 10, 2022, issue of Clinical Cancer Research. The oral medication inhibits exportin-1 (XPO-1), a major exporter of proteins from the nucleus to cytoplasm that is overexpressed in many cancers, including glioblastoma. Selinexor was approved by the FDA for the treatment of refractory multiple myeloma and relapsed/refractory diffuse large B-cell lymphoma and had pre-clinical activity against glioblastoma models. The trial sought to identify the optimal dosing schedule and evaluate the safety and efficacy of selinexor in adults with recurrent glioblastomas whose cancer had progressed following initial treatment. Reduction in tumor size was observed in 28 percent of patients, and a tolerable dose was identified for future human trials already ongoing at Columbia and collaborating sites.
Magnetic resonance contrast-enhanced axial T1 images taken throughout the course of treatment for a 36-year-old man with IDH wild-type MGMT promoter methylated GBM are shown 7 weeks before selinexor (A), at baseline 1 week before selinexor (B), and during a partial response after 16 weeks of treatment (C), and then complete (D). Response beginning after 24 weeks of treatment and confirmed after 32 weeks of treatment (not shown).

Optimizing Therapeutic Options for Patients with Lung Cancer
Weill Cornell Medicine faculty have demonstrated that the preoperative combination of immune checkpoint blockade and radiotherapy is associated with a significant enhancement of major pathological response in the treatment of early-stage non-small-cell lung cancer. Thoracic surgeons and radiation oncologists at NewYork-Presbyterian/Weill Cornell Medical Center collaborated in a study to determine if combining sub-ablative doses of radiation with immune checkpoint inhibitors have immunomodulating properties that produce potent local and systemic antitumor immune responses. They sought to establish whether preoperative anti-PDL-1 therapy with or without radiation leads to improvement in disease-free survival. Instead of performing surgery followed by immunotherapy, the immunotherapy was administered prior to surgery. Findings of their study published in the June 2021 issue of The Lancet-Oncology showed a “significant and clinically meaningful increase in the proportion of patients with a major or complete pathological response.” This combination regimen, which uses a novel, less toxic strategy of radiotherapy, has the potential to expedite preoperative therapy, reduce adverse events, and enhance efficacy.
The results of adding radiation to immune checkpoint inhibitors were shown to be quite promising, with data suggesting that radiation significantly increases the response rate.
Breakthroughs in B-Cell Cancers
Weill Cornell Medicine and Columbia faculty have uncovered new information on the roles of the microenvironment and genomic architecture underlying the development and progression of B-cell and other malignancies. Seeking to define the microenvironment’s role in diffuse large B-cell lymphoma biology.
Weill Cornell Medicine researchers found that the environment surrounding the cancerous cells of a lymphoma tumor has a strong influence on the progression of these blood-cell cancers and their responses to therapies. They also demonstrated in an animal model that by experimentally modifying the lymphoma microenvironment they could slow the cancer’s growth.
A study by Columbia researchers indicates that errors in the way chromosomes are packed into antibody-producing B cells appear to play a role in the development of B-cell-related blood cancers. In a mouse model, they showed that the protein DIS3 is critical in maintaining genomic architecture and preventing uncontrolled chromosome rearrangements that have the potential to cause cancer. Their findings could lead to the identification of new biomarkers for predicting the onset of these cancers and to a new class of cancer therapies that prevents or corrects harmful changes in the genomic architecture.
Cancer specialists at NewYork-Presbyterian Hospital are making strides in the understanding of challenging blood cancers.

Making Headway in Treatment for Esophageal Cancer
Columbia researchers have uncovered a new potential therapeutic target for lung metastasis that originated in esophageal squamous cell carcinoma. Their study, published in the April 1, 2021, issue of Genes and Development, identifies in mouse models the role of the BIRC-5 gene and Survivin, the anti-apotic protein it encodes, in metastasis of esophageal squamous cell carcinoma and potentially its role in Survivin-dependent GI cancers. This is the first study to provide evidence of the role of Survivin in tumor metastasis and to identify mutant p53 as a key component in regulating Survivin expression.
Weill Cornell Medicine served as a lead site for two phase 3 clinical trials that demonstrated pembrolizumab is a safe and effective option when combined with chemotherapy as initial treatment for advanced esophageal carcinoma. The drug was also shown to be effective as a single drug treatment for patients with locally advanced and metastatic squamous cell esophageal cancer who have already received standard chemotherapy. The study’s findings, which were published in the October 6, 2020, issue of the Journal of Clinical Oncology, contributed to the FDA’s approval of pembrolizumab as a second-line treatment for patients with advanced/metastatic squamous cell carcinoma or adenocarcinoma.
Esophageal squamous cell carcinoma is the focus of seminal research published by gastroenterology faculty at Columbia and Weill Cornell Medicine.



